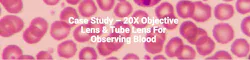
65fc75c01466af001ef0616b Screenshot 20240321 At 1 65fc75c01466af001ef0616b Screenshot 20240321 At 1

Case Study – 20X Objective Lens & Tube Lens For Observing Blood
Introduction
This 20x objective lens is designed and optimized for a world-renowed medical company for the observation of human blood. Its outstanding resolution is highly useful for applications in biological contact. Its high magnification capability enables clear visualization and high resolution of extremely small sized cells and its biological structures. This customer application aims to explore in-depth the subtle changes in human blood by using the 20x objective lens in order to reveal potential disease indicators and physiological processes. Through the use of advanced microscopy techniques, we will examine the morphology, quantity, and trajectory of blood cellsin order to provide more accurate information for clinical diagnosis and medical treatment. This biological microscopy design and application hold significant importance in gaining a profound understanding of the microcosm of blood and in advancing the field of medical science. Our engineering team works tirelessly to customize and optimize its optical performance in order to achieve maximum effects.
Project overview
This medical research project with Avantier employs a 20X objective lens to investigate human blood samples, focusing on the exploration of single-cell genetic expression and single-cell immune profiling. Leveraging the high magnification capabilities of the 20X objective lens allows for a meticulous examination and analysis at the single-cell level. This approach provides a comprehensive understanding of genetic expression patterns, immune responses, chromatin accessibility, genetic information via linked reads, and the spatial distribution of gene expression in fresh-frozen samples. The implementation of this method contributes to the advancement of knowledge across various facets of single-cell biology and genomics.